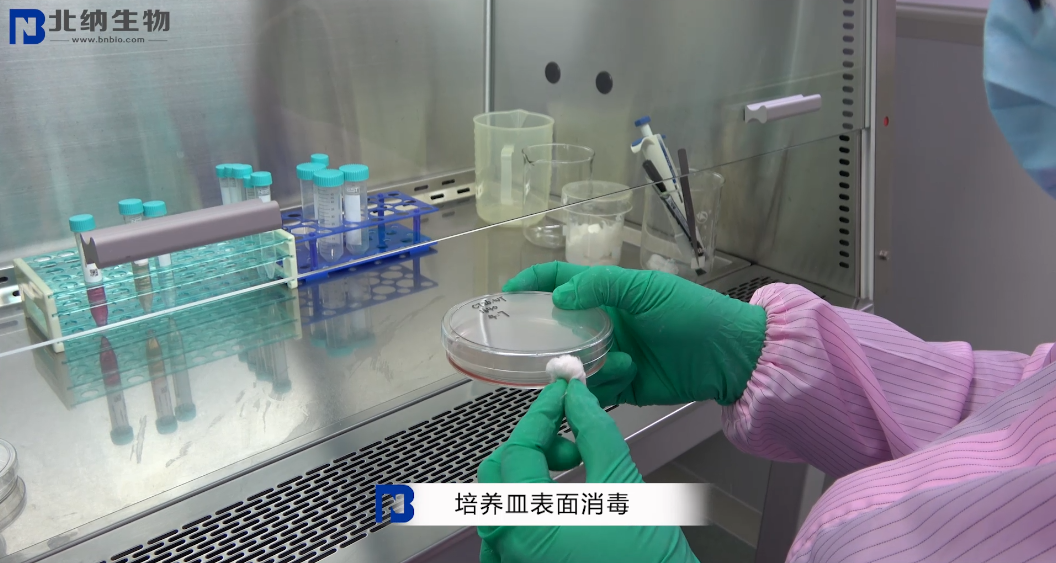
新闻图片3
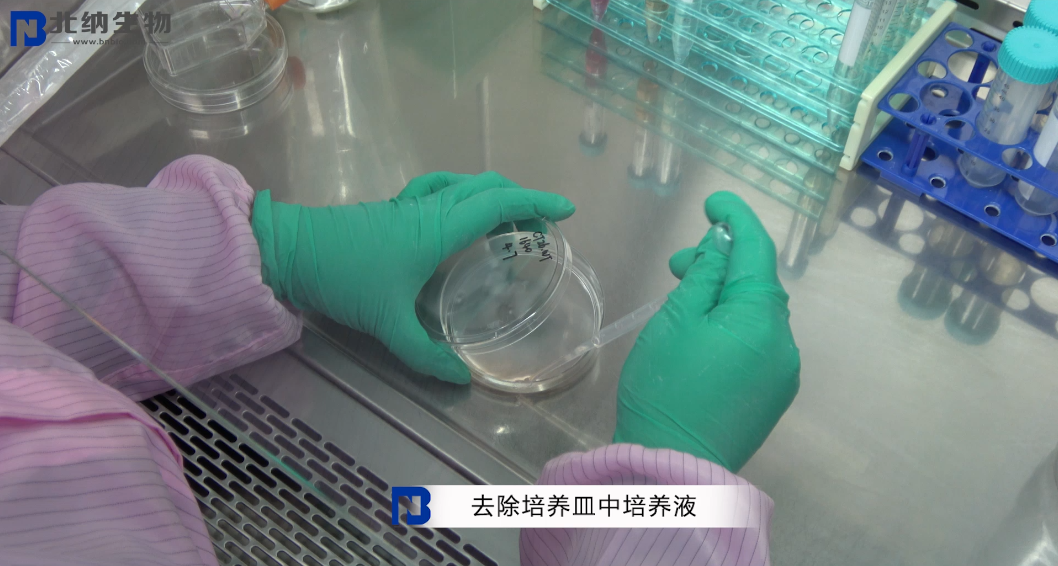
新闻图片4
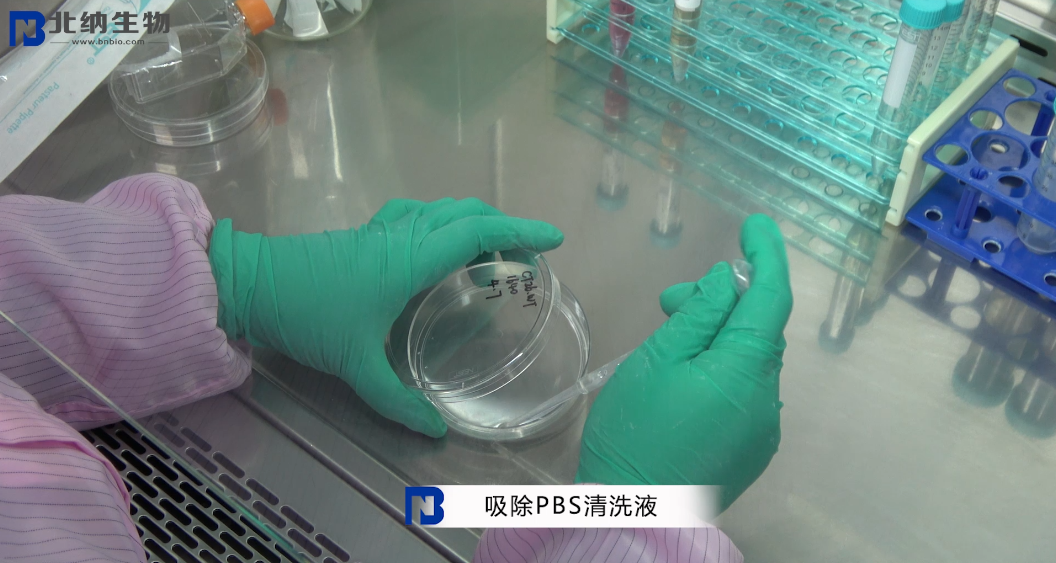
新闻图片7
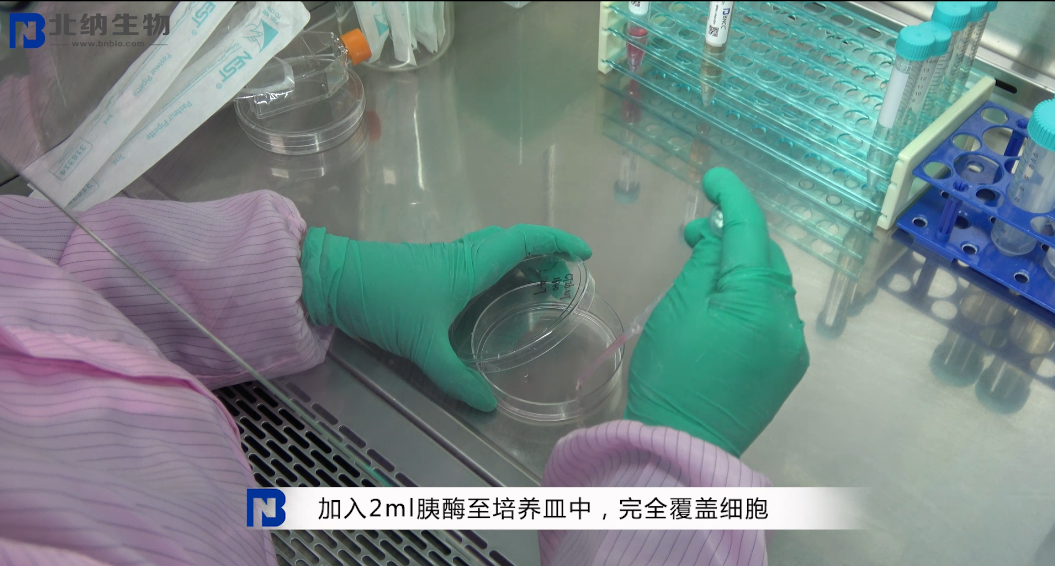
新闻图片9
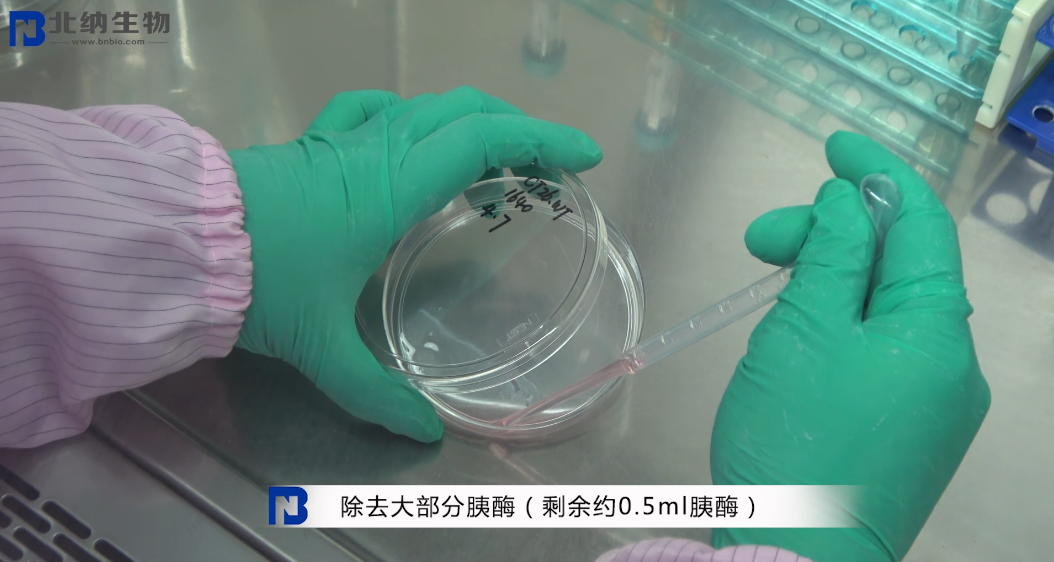
新闻图片12
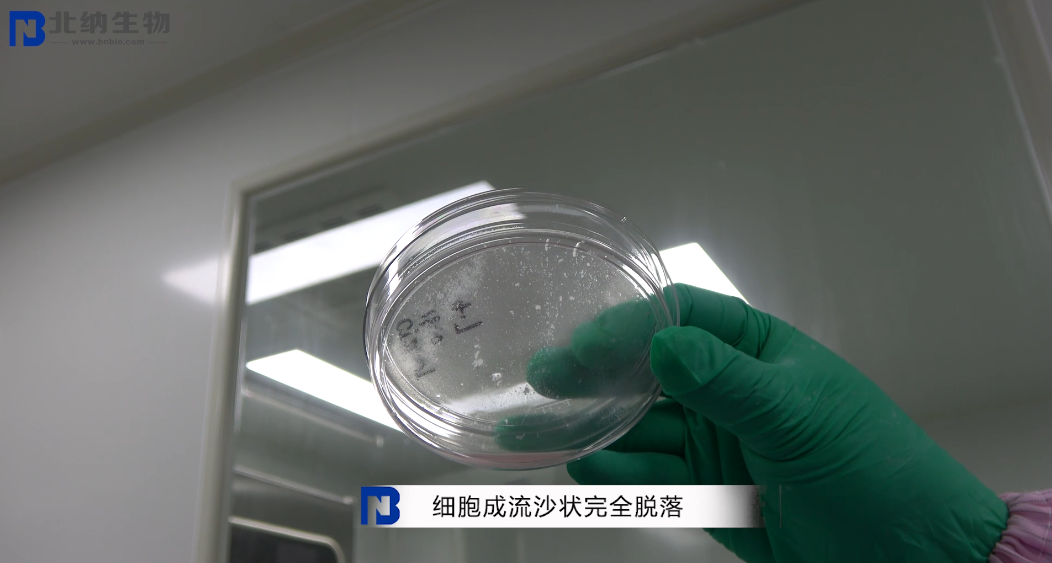
新闻图片15
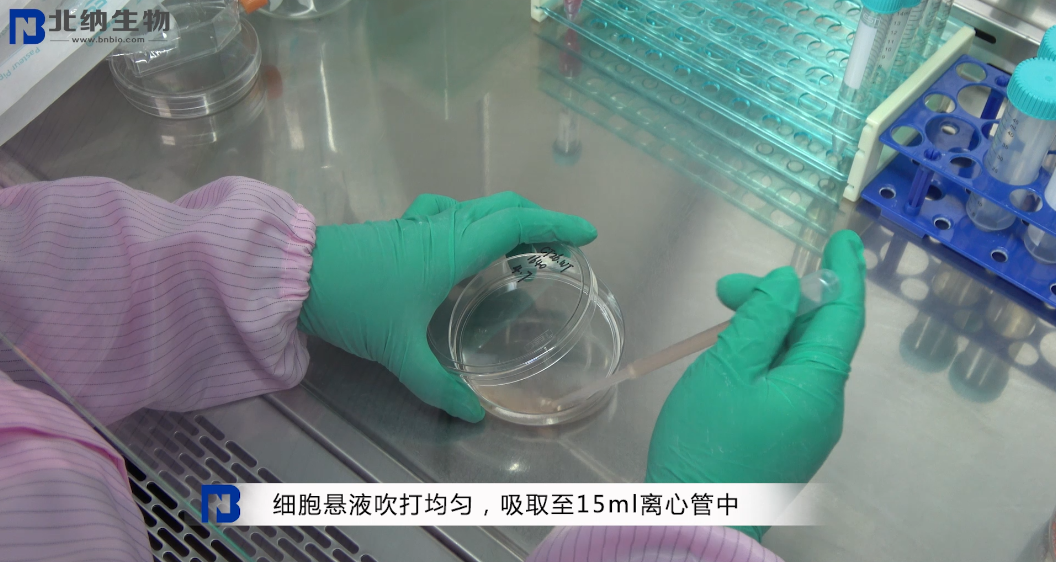
新闻图片17

北京北纳创联生物技术研究院
14 年
手机商铺
商家活跃:
产品热度:
- NaN
- 0.20000000000000018
- 0.20000000000000018
- 2.2
- 2.2
紫色红曲
询价
推荐产品
公司新闻/正文
贴壁细胞的保藏方法
1404 人阅读发布时间:2020-06-02 10:16
所谓细胞虐我千百遍,我待细胞如初恋。细胞培养过程中,总是会出现各种意想不到的问题,一不留神就会全盘皆输。
对于实验操作不太熟悉的朋友,与其一边做着科研一边拜着上帝祈祷实验成功,不如看看北纳生物技术老师如何操作。
今天要学习的是贴壁细胞的保藏方法,大家赶紧拿出小本本认真听讲吧!
一、观察细胞状态
贴壁细胞密度达到 80%,即可以细胞冻存形式进行保藏,拍照,记录细胞状态;

二、细胞清洗
培养皿表面消毒后,转移至生物安全柜中,去除培养皿中培养液,加入 12 ml PBS,轻轻摇晃培养皿清洗细胞,随后吸除 PBS 清洗液;




三、细胞消化
将 2 ml 胰酶加入培养皿中,完全覆盖细胞,置于显微镜下观察(期间禁止摇晃培养皿),当细胞刚开始脱落时,立即转移至生物安全柜中,除去大部分胰酶,剩余约 0.5 ml 胰酶,转移至培养箱内继续消化,每 30 秒肉眼观察细胞状态,至细胞成流沙状完全脱落,转移至生物安全柜中,加入 12 ml 完全培养基,终止消化;









四、细胞离心
将终止消化后的细胞悬液吹打均匀,吸取至 15 ml 离心管中,1000 r/min(110 g),离心 3 min;


五、细胞冻存
离心后去除细胞上清液,按照冻存细胞量 5*10^5/ml,吸取冻存液重悬细胞沉淀,吹打均匀后分装至相应的冻存管中,进行冻存;


六、细胞保藏
冻存管做好标记,放至程序降温盒中,于 4 ℃ 冰箱放置 30 min,转移至 -80 ℃ 超低温冰箱过夜,将过夜后的冻存细胞转移至液氮中保藏。




贴壁细胞的保藏方法您 GET 到了吗?如果对于实验操作还有疑问或者需要其他的技术指导,欢迎致电 010-58103778,我们一定悉心为您解答。
对于实验操作不太熟悉的朋友,与其一边做着科研一边拜着上帝祈祷实验成功,不如看看北纳生物技术老师如何操作。
今天要学习的是贴壁细胞的保藏方法,大家赶紧拿出小本本认真听讲吧!
一、观察细胞状态
贴壁细胞密度达到 80%,即可以细胞冻存形式进行保藏,拍照,记录细胞状态;


二、细胞清洗
培养皿表面消毒后,转移至生物安全柜中,去除培养皿中培养液,加入 12 ml PBS,轻轻摇晃培养皿清洗细胞,随后吸除 PBS 清洗液;

三、细胞消化
将 2 ml 胰酶加入培养皿中,完全覆盖细胞,置于显微镜下观察(期间禁止摇晃培养皿),当细胞刚开始脱落时,立即转移至生物安全柜中,除去大部分胰酶,剩余约 0.5 ml 胰酶,转移至培养箱内继续消化,每 30 秒肉眼观察细胞状态,至细胞成流沙状完全脱落,转移至生物安全柜中,加入 12 ml 完全培养基,终止消化;

四、细胞离心
将终止消化后的细胞悬液吹打均匀,吸取至 15 ml 离心管中,1000 r/min(110 g),离心 3 min;

五、细胞冻存
离心后去除细胞上清液,按照冻存细胞量 5*10^5/ml,吸取冻存液重悬细胞沉淀,吹打均匀后分装至相应的冻存管中,进行冻存;



六、细胞保藏
冻存管做好标记,放至程序降温盒中,于 4 ℃ 冰箱放置 30 min,转移至 -80 ℃ 超低温冰箱过夜,将过夜后的冻存细胞转移至液氮中保藏。




贴壁细胞的保藏方法您 GET 到了吗?如果对于实验操作还有疑问或者需要其他的技术指导,欢迎致电 010-58103778,我们一定悉心为您解答。




